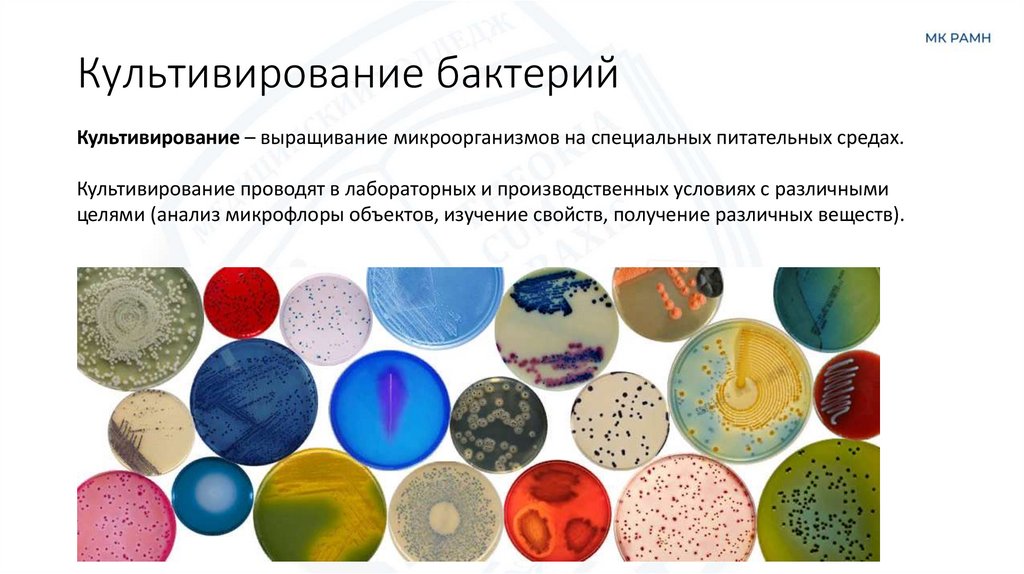
Культивирование бактерий
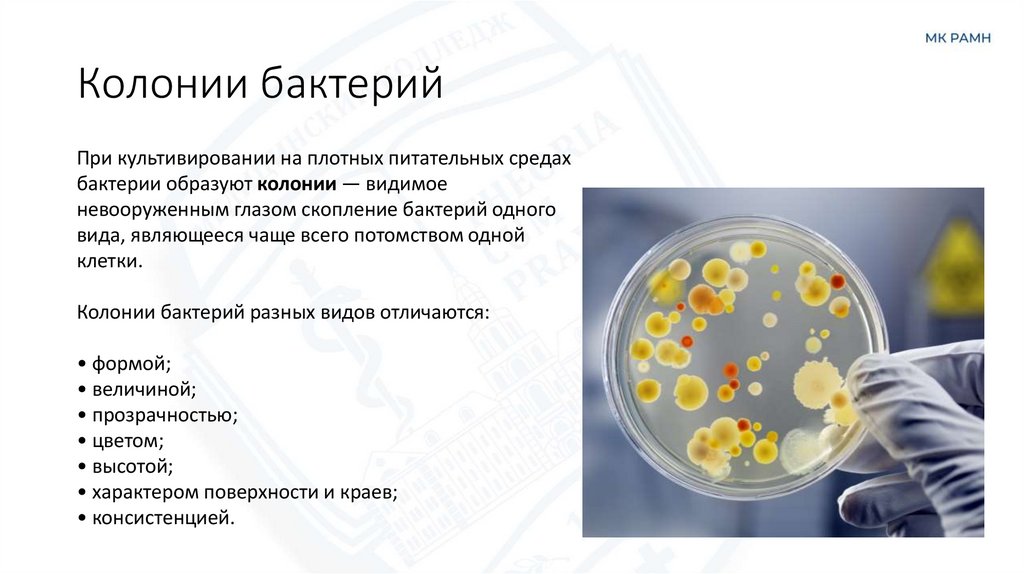
Колонии бактерий

Похожие презентации:
Лекция 17 Питание микроорганизмов
1. Лекция 17 Питание микроорганизмов
Преподаватель Гордеева Е.В.2.
3.
4. Транспорт питательных веществ
Основным регулятором поступления веществ в бактериальную клеткуявляется цитоплазматическая мембрана.
Существует два типа переноса веществ в бактериальную клетку:
Пассивный
Активный
Идет без затрат
энергии
Идет с затратой
энергии
5. Пассивный транспорт
При пассивном переносе вещество проникает в клетку только по градиенту концентрации.Затрат энергии при этом не происходит.
Простая диффузия —
неспецифическое
проникновение по градиенту
концентрации веществ в клетку.
Осуществляется до тех пор, пока
концентрация вещества не будет
равной по обе стороны
мембраны (внутри и вне клетки).
6. Пассивный транспорт
При пассивном переносе вещество проникает в клетку только по градиенту концентрации.Затрат энергии при этом не происходит.
Облегченная диффузия протекает по
градиенту концентрации при
обязательном участии специфических
белков – пермеаз, локализованных в
мембране.
7. Активный транспорт
При активном переносе вещество проникает вклетку против градиента концентрации при
помощи белка-переносчика — пермеазы.
При этом происходит затрата энергии, так как
этот процесс происходит тогда, концентрация
вещества в микробной клетке выше чем в
питательной среде.
Имеется два типа активного транспорта.
8. Активный транспорт
Активный транспортТранслокация радикалов
- против градиента
концентрации,
субстратспецифичен,
энергозатратный (за счет АТФ),
вещества поступают в клетку в
химически неизмененном
виде.
- против градиента
концентрации, с помощью
фосфотрансферазной системы,
вещества (преимущественно
сахара) поступают в клетку в
форфорилированном виде.
Выход веществ из клетки осуществляется за счет диффузии и при участии транспортных
систем.
9. Рост и развитие прокариот
Рост – это увеличение массы клетки вследствие формирования всех клеточныхструктур.
Размножение – это увеличение количества клеток в колонии.
Бинарное деление
Различают
Почкование
Генетическую рекомбинацию
10. Бинарное деление
Процесс начинается с удвоениябактериальной хромосомы
(нуклеоида) и протекает в
несколько этапов:
• клетка удлиняется;
• наружная оболочка «врастает»
внутрь и образует поперечную
перегородку (перетяжку);
• две новые (дочерние) клетки
расходятся в разные стороны.
В результате получаются два
идентичных организма.
11. Почкование
Отдельные микроорганизмы делятся почкованием, но это скорее исключение из общегоправила.
Процесс заключается в образовании на одном из полюсов клетки короткого выступа, в
который «дрейфует» одна из половин разделившегося нуклеоида. Затем выступ
разрастается и отделяется от материнской клетки.
12. Генетическая рекомбинация
Существуют три способа передачи генетической информации:• конъюгация – прямая передача (не обмен) части ДНК при контакте от
одной бактерии к другой (процесс идет в одном направлении);
• трансдукция – перенос фрагмента ДНК с помощью бактериофага
(вируса бактерий);
• трансформация – поглощение генетической информации отмерших
или уничтоженных клеток из окружающей среды.
13. Культивирование бактерий
Культивирование – выращивание микроорганизмов на специальных питательных средах.Культивирование проводят в лабораторных и производственных условиях с различными
целями (анализ микрофлоры объектов, изучение свойств, получение различных веществ).
14. Проточное культивирование
Проточное культивирование (непрерывнаякультура) позволяет получать большие массы
бактерий при проточном культивировании в
специальных устройствах (хемостатах и
турбидистатах) и используется при
производстве вакцин, а также в
биотехнологии для получения различных
биологически активных веществ,
продуцируемых микроорганизмами.
15. Колонии бактерий
При культивировании на плотных питательных средахбактерии образуют колонии — видимое
невооруженным глазом скопление бактерий одного
вида, являющееся чаще всего потомством одной
клетки.
Колонии бактерий разных видов отличаются:
• формой;
• величиной;
• прозрачностью;
• цветом;
• высотой;
• характером поверхности и краев;
• консистенцией.
16. Размножение бактерий в закрытой среде
При изучении процесса размножения бактерий необходимо учитывать, что бактерии всегдасуществуют в виде более или менее многочисленных популяций, и развитие бактериальной
популяции в жидкой питательной среде в периодической культуре можно рассматривать как
замкнутую систему.
17. Онтогенез бактерий
1. Вегетативная форма, находящаяся в состоянии роста и размножения, жизнеспособная ижизнедеятельная.
2. Покоящиеся формы — жизнеспособные, но не жизнедеятельные формы (стадии) развития
микроорганизмов с резко сниженным обменом веществ и энергии. У них:
• более толстая оболочка, малопроницаемая для различных химических веществ; меньшее
содержание воды;
• отсутствуют рост и размножение;
• понижен метаболизм (гипобиоз, анабиоз), отсутствует выделение токсинов и ферментов;
• повышена резистентность к повреждающим факторам внешней среды (антибиотикам,
антисептикам, дезинфектантам, температуре) и иммунным факторам организма человека;
• они способны долгое время переживать в организме или во внешней среде.
18. Покоящиеся формы бактерий
К покоящимся формам относят:споры бактерий и грибов; они образуются во внешней среде;
цисты спирохет и простейших; они образуются в организме человека;
«малые» формы риккетсий;
элементарные тельца хламидий;
С некоторыми оговорками к покоящимся формам относят:
• L–формы бактерий
19. Споры
Спорообразование - способ сохранения определенных видов бактерий в неблагоприятныхусловиях среды.
Эндоспоры образуются в цитоплазме, представляют собой клетки с низкой метаболической
активностью и высокой устойчивостью к высушиванию, действию различных факторов и др.
20. Споры
• Расположение и размеры спор у различныхмикроорганизмов отличается, что имеет
таксономическое значение.
• Основные фазы “жизненного цикла” спор споруляция (включает подготовительную
стадию, стадию предспоры, образования
оболочки, созревания и покоя) и
прорастание, заканчивающееся
образованием вегетативной формы.
• Процесс спорообразования генетически
обусловлен.
21. Некультивируемые формы бактерий.
У многих видов грамотрицательных бактерий, не образующих спор, существуетособое приспособительное состояние - некультивируемые формы.
• Они обладают низкой метаболической активностью и активно не размножаются,
т.е. не образуют колоний на плотных питательных средах, при посевах не
выявляются.
• Обладают высокой устойчивостью и могут сохранять жизнеспособность в течение
нескольких лет.
• Не выявляются классическими бактериологическими методами, обнаруживаются
только при помощи генетических методов (полимеразной цепной реакции- ПЦР).
21

Биология
Биология








